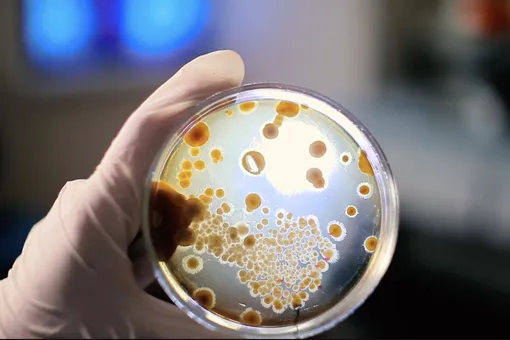
Одежда с бактериями: инновационный способ защиты людей от радиации Одежда с бактериями: инновационный способ защиты людей от радиации

Команда шотландских ученых и дизайнер Кэти Таббинг разрабатывают новую ткань – пропитанную специальными микроорганизмами. Это не только позволит космонавтам контролировать радиационный уровень во время длительных миссиях, но и обеспечить безопасность людей, находящихся в опасных радиационных зонах на Земле.
Одежда с бактериями: инновационный способ защиты людей от радиации
Процесс создания ткани основан на 3D-печати и слоистом покрытии с различными цветами. Бактерии из-за радиации теряют пигмент, слои один за другим выгорают, что и позволяет в итоге увидеть текущий уровень облучения. И, главное, все происходит естественным путем, каких-либо измерительных приборов не требуется.

Опыты в космосе
Материал планируют запустить на орбиту сначала с помощью мини-спутника. Исследователи оценят, как меняется цвет ткани в космических условиях, моделируя многомесячное воздействие радиации. В случае удачного результата опыты расширятся, и в 2028 году ткань отправится уже на Луну.
На Земле же подобная одежда тоже пригодится: например, она защитит медиков, работающих с рентгеновскими аппаратами, а еще может служить средством контроля солнечного излучения, снижая риск появления рака кожи.
Процесс создания такого материала объединил сразу несколько отраслей – биологию, инженерию и моду. В итоге получается функциональный и эстетичный продукт.
Проект открывает новые горизонты в использовании органических материалов для радиоактивного мониторинга и исследует возможности взаимодействия междисциплинарных технологий с космическими и земными задачами.

